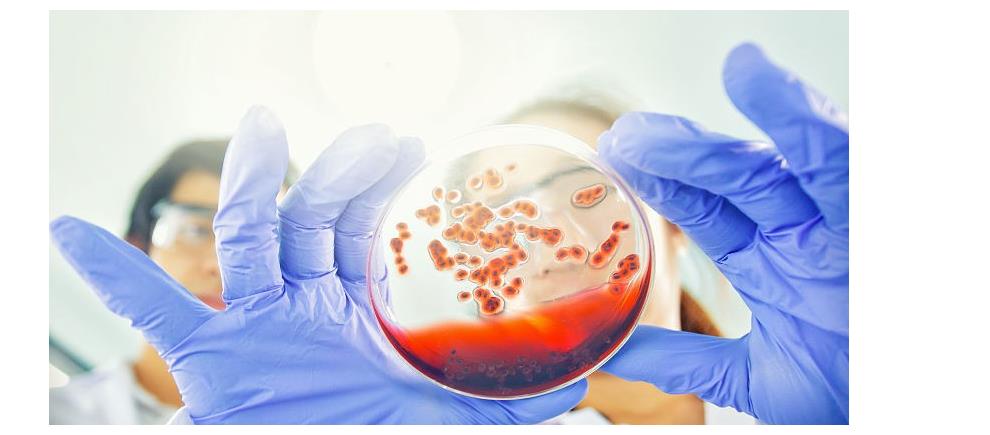

艾滋病的危害,我想大家应该是众所周知,其实艾滋病并不像我们想象的那么少见,其实在临床工作中,就会发现这几年艾滋病患病人数在增加。
2021年7月14日,联合国艾滋病规划署发布《直面不平等—2021艾滋病防治全球进展报告》中显示:我国现存艾滋病感染者104.5万例。
艾滋病患者早期症状并不明显,但是部分艾滋病患者的皮肤会出现一些特征性改变,而很多患者却把这些特征性改变误认为是皮肤病,而错过就诊。
我上个月接诊一位患者,老胡就是这个情况。
老胡今年62岁,退休后就跟着老婆来到省会帮自己的儿子带孙子,刚刚来到城市,老胡觉得生活得非常不习惯,老友都不在身边,觉得非常孤独。
儿子看自己老爸这么无聊,于是给老胡报了一个交际舞学习班。一开始老胡也比较排斥,要自己老婆陪着一起去,但是老胡老婆觉得自己膝关节疼痛不适合去,后面在全家人的怂恿下老胡还是选择了去试一试。

去过几次老胡就认识了很多舞友,而且舞友经常会组织活动,从那以后老胡的生活变得多姿多彩,不亦乐乎。
可是最近老胡发现自己的皮肤总是经常出现一些不明原因的疱疹,一开始老胡觉得只是皮肤病,于是就自己买一些膏药涂一涂,但是过了几个月都没有好转,而且最近老胡还出现了反复低热,不得已老胡来到了我门诊。
根据老胡的症状,我有怀疑他是艾滋病。
于是我给老胡安排了HIV抗体检测,结果出来,显示HIV为阳性,这基本就断定老胡是艾滋病毒的携带者,为了明确分型,我又给老胡安排了HIV-1和HIV-2等进一步检查,检测结果时HIV-1为阳性。随后我们给老胡做了HIV-RNA定量检查,结果显示HIV-RNA结果超过正常范围,确诊为1型艾滋病毒。

询问老胡病史后,主要考虑老胡和舞友存在不洁的生活史造成的。
一、艾滋病是什么?
艾滋病死亡率很高。它的病原体是一种逆转录病毒,当人体感染此种病毒后,通过一系列的化学作用最终破坏人类的防御系统一T淋巴细胞,而被攻击和破坏的其中是一种辅助性T细胞,它的破裂、溶解、消失,使人体的免疫功能瓦解,而且这种病毒的感染还可诱发恶生肿瘤。

二、若皮肤出现3种情况,可能是艾滋病找上门。
1、反复发作的疱疹
因为艾滋病病毒入侵造成免疫系统破坏,部分艾滋病皮肤会出现特征性反复发作的疱疹。
2、红色丘斑疹
感染艾滋病病毒的初期2-4周内,部分患者会出现类似流感一样的症状,出现红色丘斑疹,经常还会伴有反复低热症状。

3、皮肤瘙痒。
艾滋病患者,早期还会常常出现瘙痒性丘疹样皮炎,而且这些皮炎常常出现在腿和手臂。因剧烈很痒,反复挠刮,导致出血感染